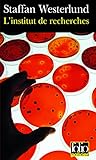
L'Institut de recherches: Une enquête d'Inga-Lisa Östergren

- Achat Livres -> Littérature -> Policiers
L'Institut de recherches: Une enquête d'Inga-Lisa Östergren

1,00 €
Etat : Très bon état
Auteur(s) : Staffan Westerlund
Date de publication : 20-01-2005
Edition : Folio
Type : Poche
EAN 13 : 9782070314171
Comparateur de prix pour L'Institut de recherches: Une enquête d'Inga-Lisa Östergren
| Marchand | |
|---|---|

| Voir l'offre |

| Voir l'offre |

| Voir l'offre |
Cette page contient des liens d'affiliation. Lorsque vous cliquez sur les liens des sites marchands et effectuez un achat, ce site peut percevoir une commission, sans surcoût pour vous. Les programmes d'affiliation incluent, sans s'y limiter, eBay Partner Network et Amazon.
Offre(s) pour L'Institut de recherches: Une enquête d'Inga-Lisa Östergren
| Expedié par | État | Prix | J'achète |
|---|---|---|---|
| Roneila68 | Très bon état | 1,00 € | Vous devez être connecté |
Quelque chose à dire au sujet de ce livre?
Aucune critique pour le moment
Le livre a bien été ajouté au panier
L'Institut de recherches: Une enquête d'Inga-Lisa Östergren
Etat : N/A
Prix : 0,00 €
Total, 0 livre : 0,00 €
+ Nos Rayons
- + Littérature
- + Jeunesse
- + Art & culture
- + Sciences humaines
- + BD, Manga & Comics
- + Histoire, actualité, politique
- + Manuels scolaires
-
+ Tourisme
- Guides touristiques Monde Afrique
- Guides touristiques Monde Angleterre-Londres
- Tourisme hors France Guides pratiques
- Guides touristiques Monde Portugal
- Guides touristiques France Provence-Alpes-Côte
- Guides touristiques France France
- Guides touristiques Monde Suisse
- Guides touristiques Monde Caraïbes
- Guides touristiques Monde Italie-Sicile-Sardaig
- Guides touristiques Monde Espagne
- + Sports & loisirs
- + Cuisine
- + Economie & entreprise
- + Nature
- + Développement durable

